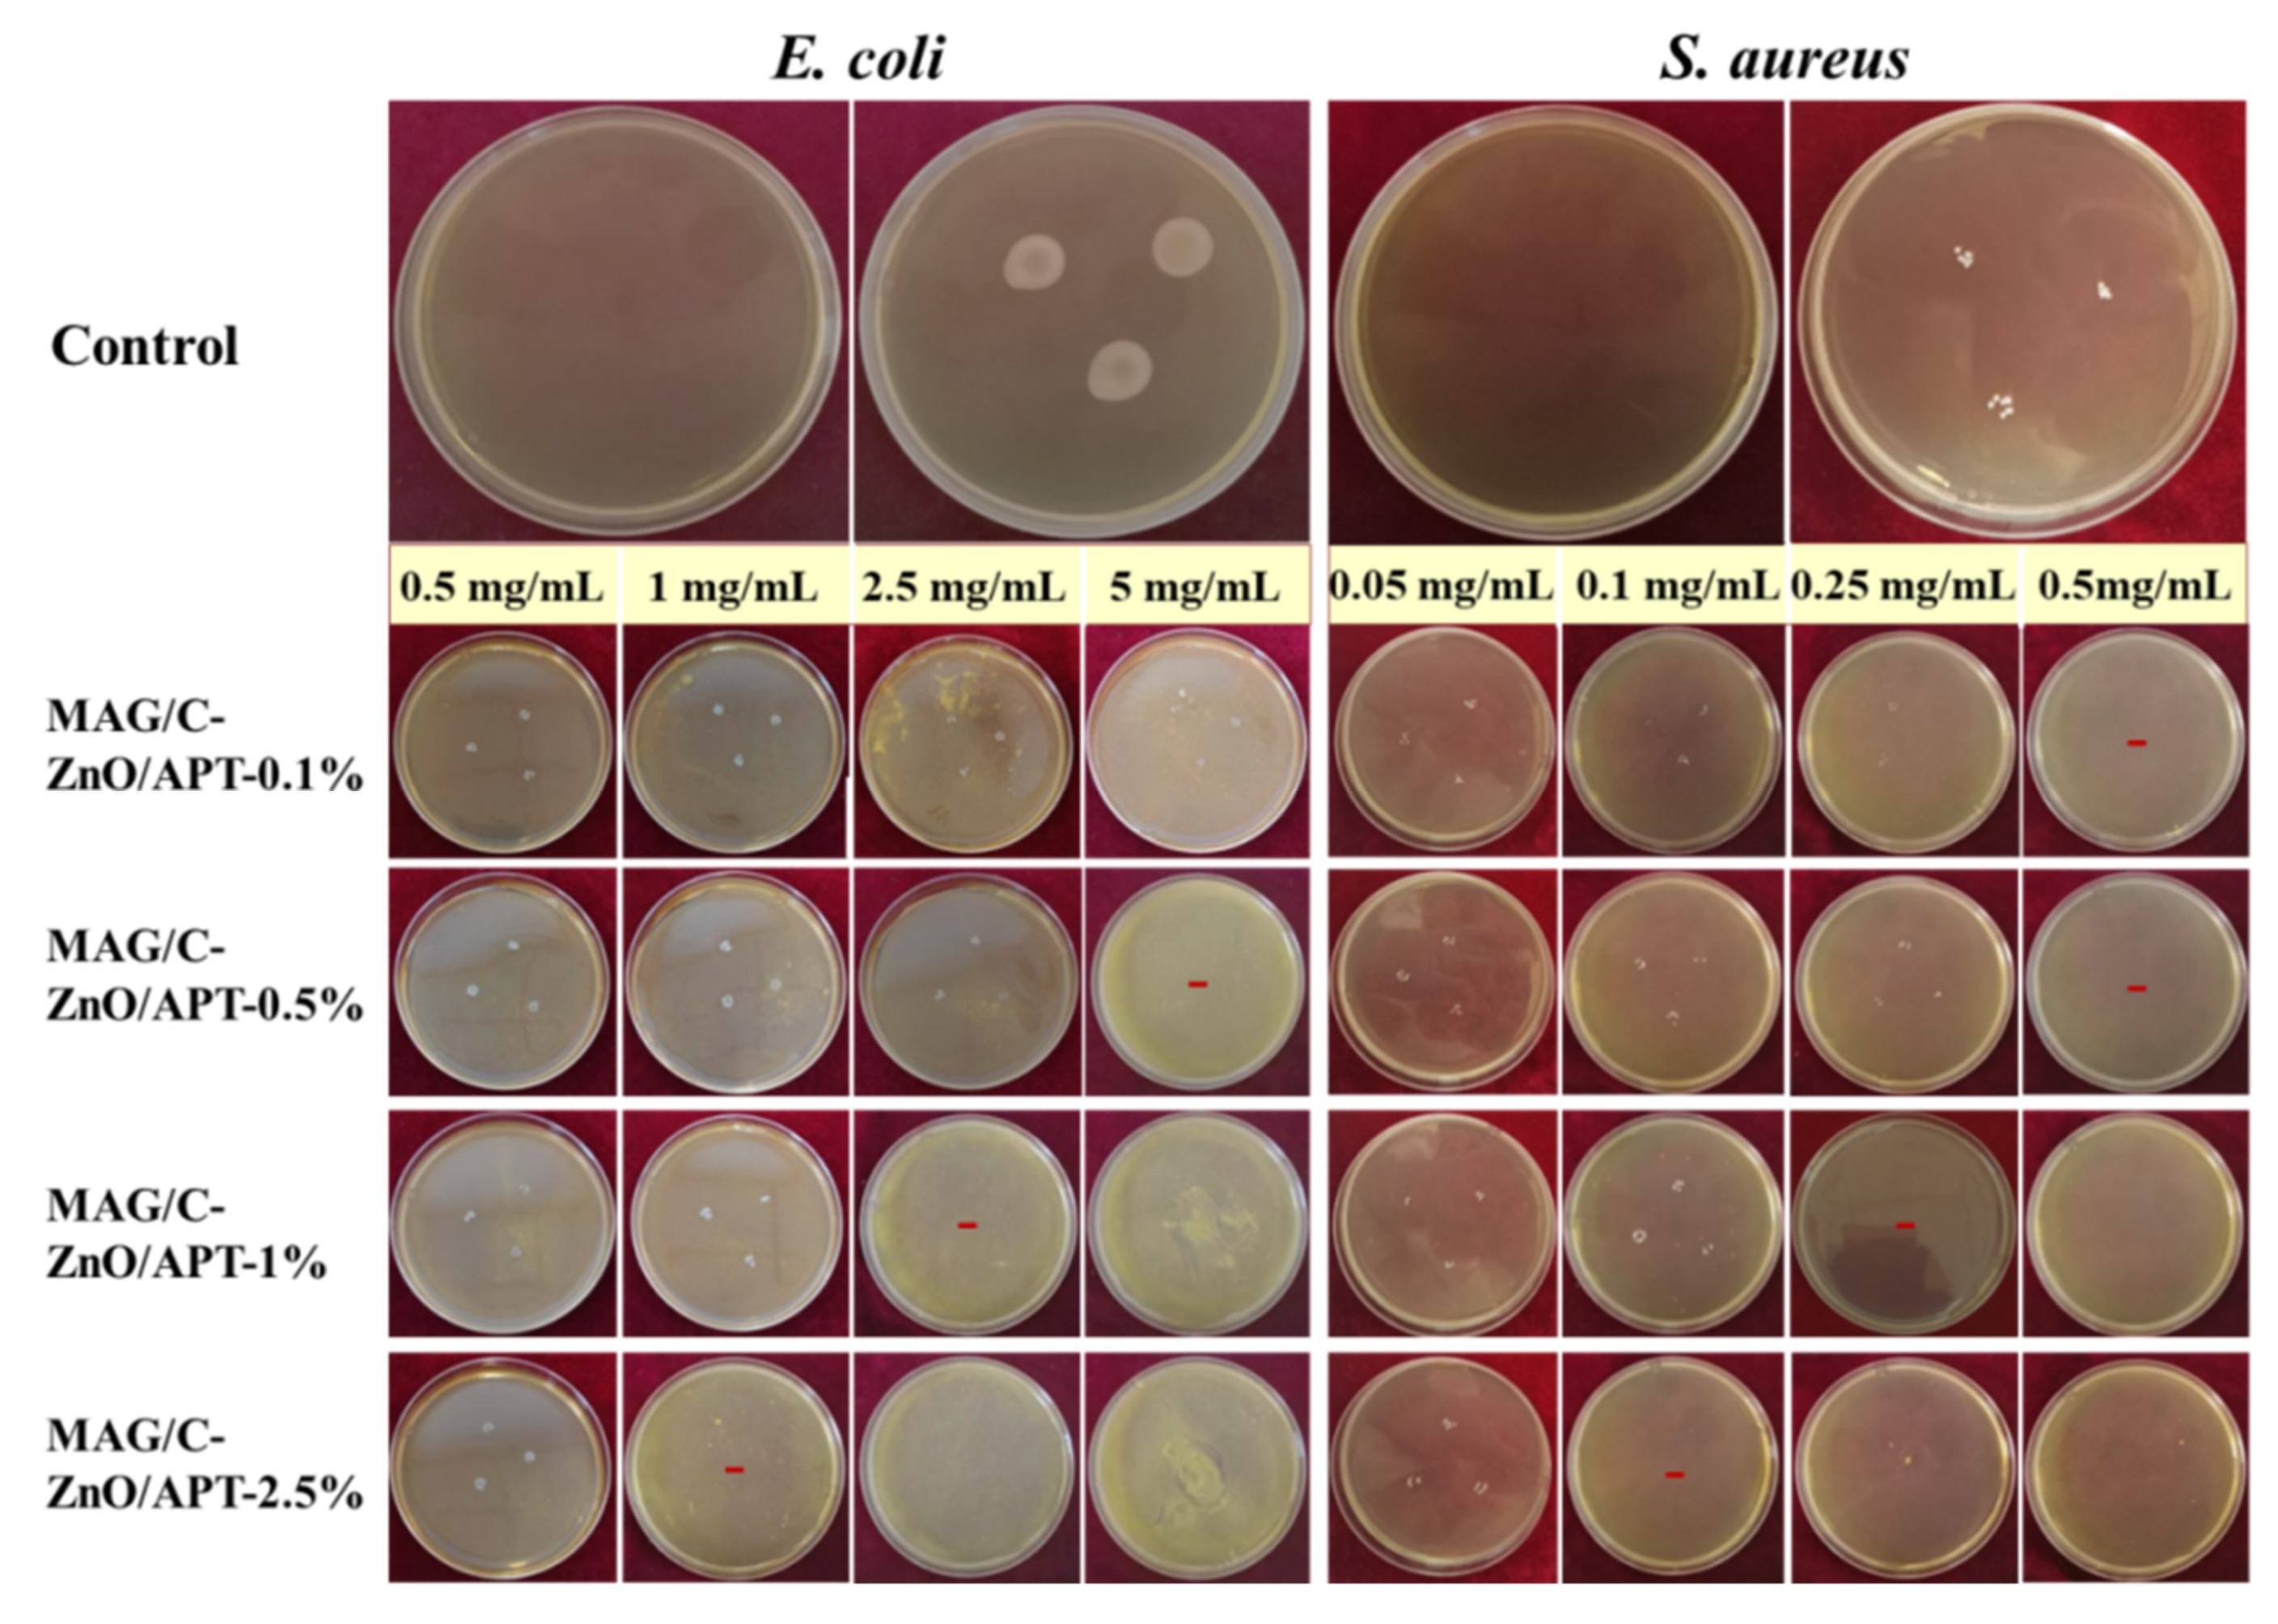
Minerals 12 00364 g005
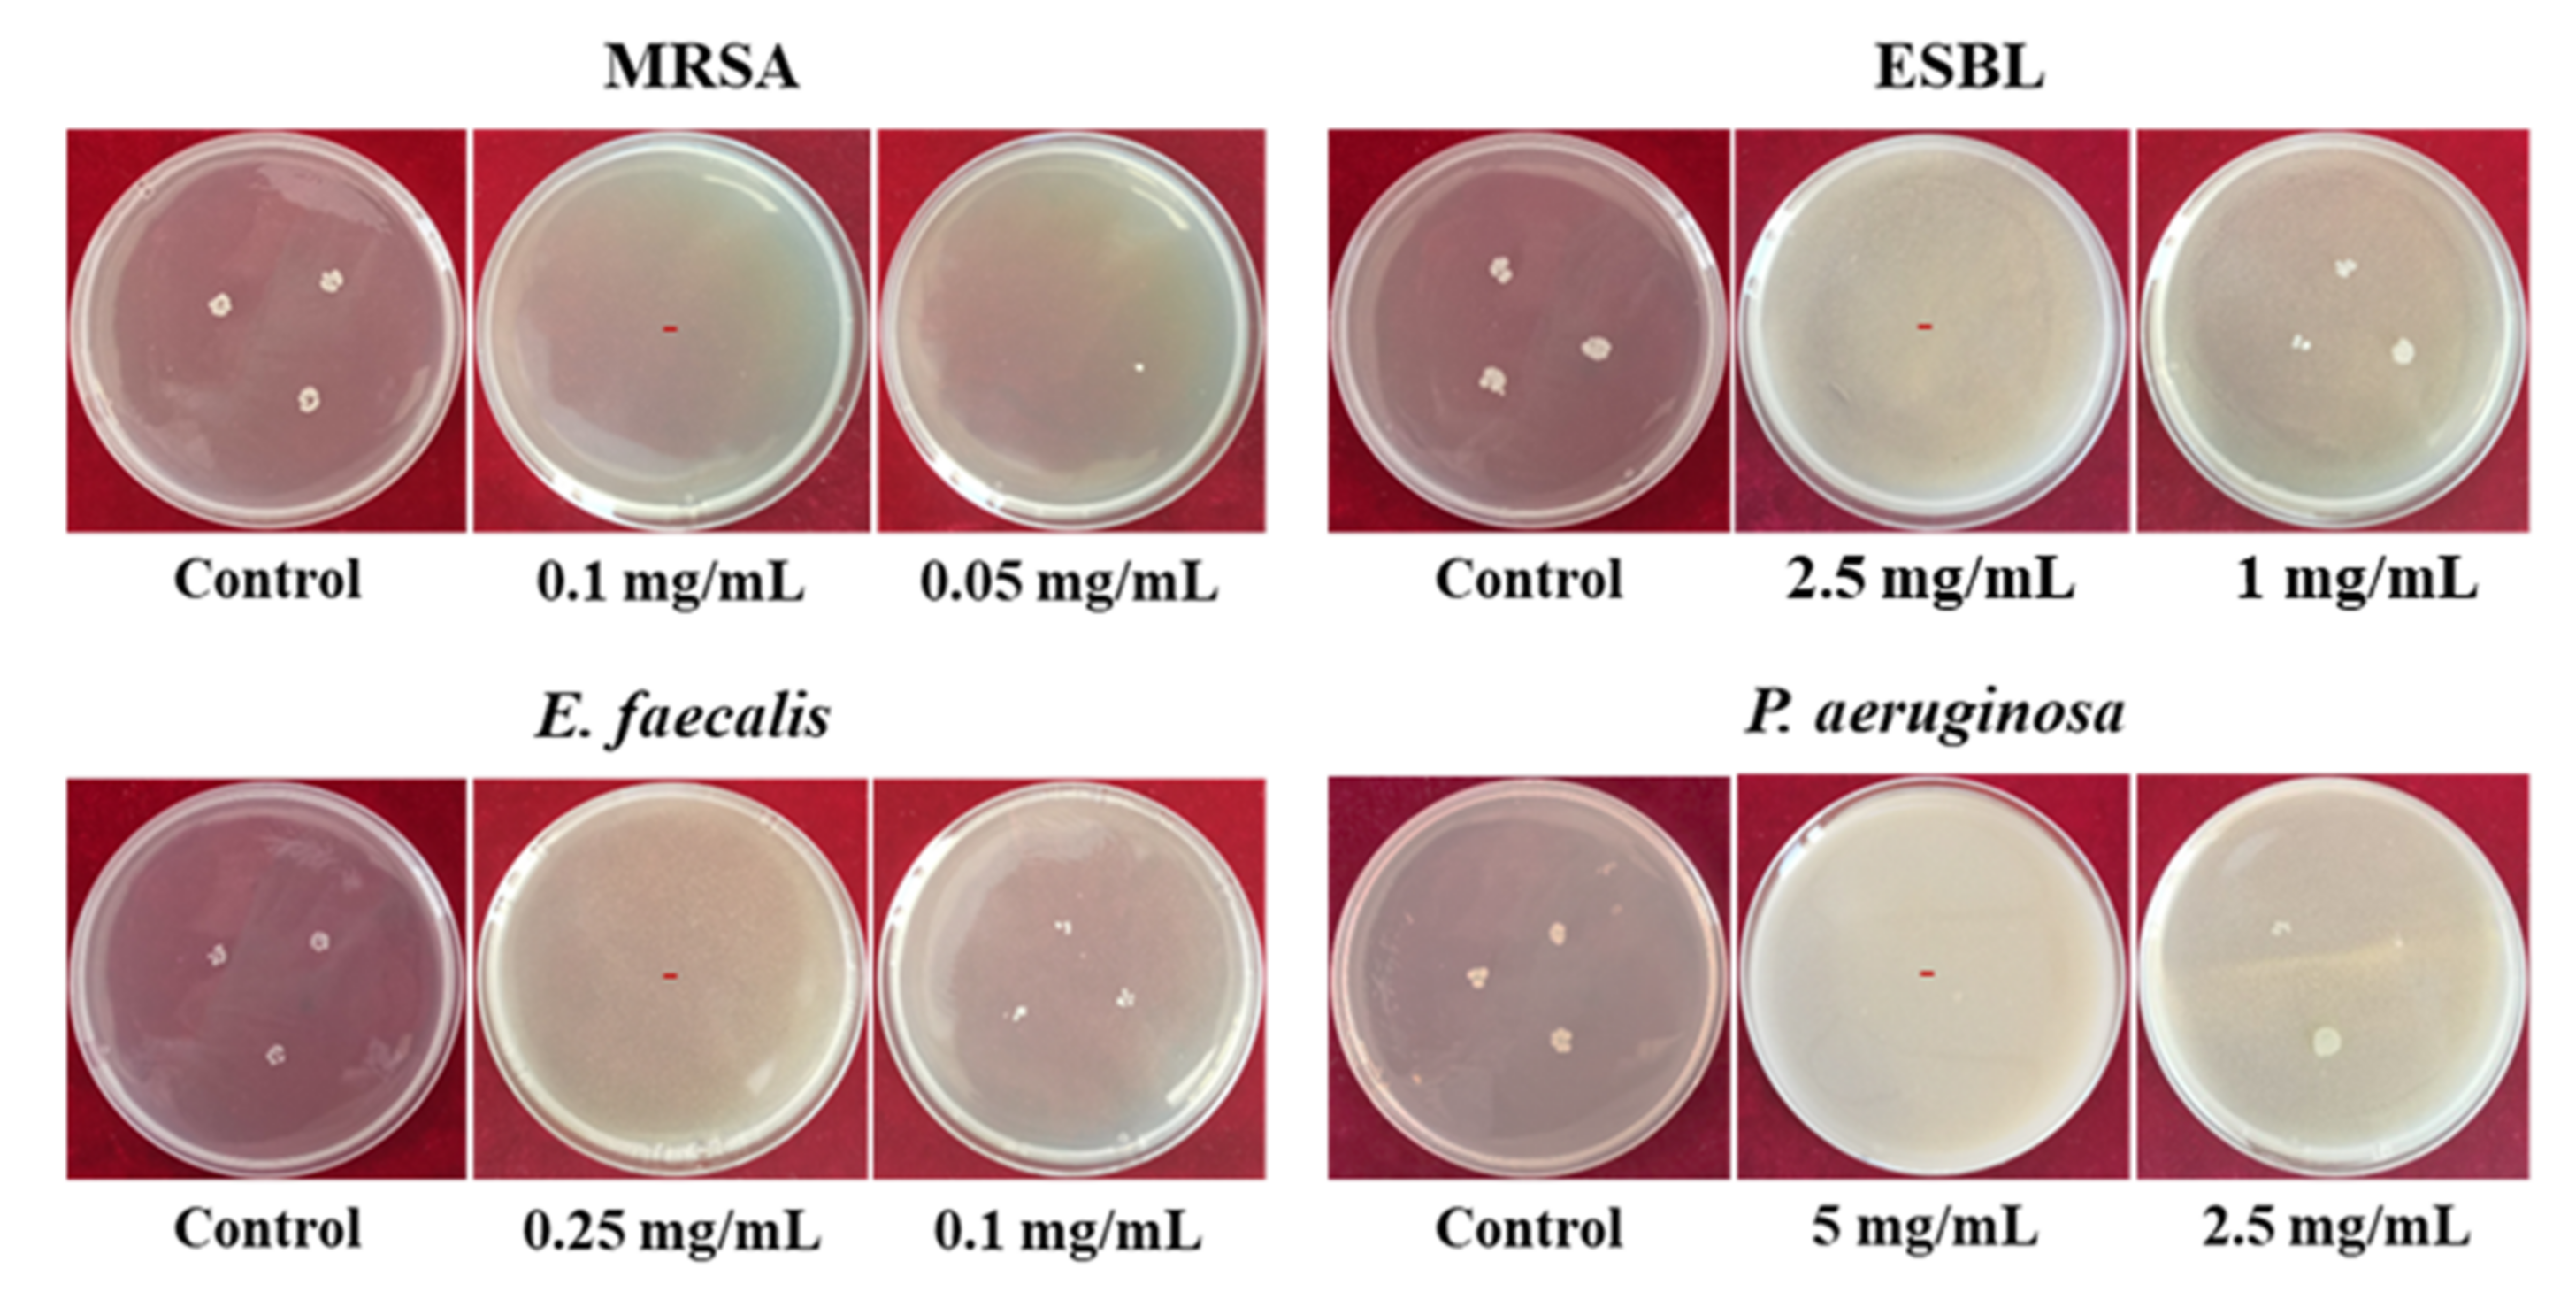
Minerals 12 00364 g006

Facile Preparation of Organo-Modified ZnO/Attapulgite Nanocomposites Loaded with Monoammonium Glycyrrhizinate via Mechanical Milling and Their Synergistic Antibacterial Effect
Abstract
:1. Introduction
2. Materials and Methods
2.1. Materials
2.2. ZnO/APT Nanocomposite Preparation and Modification
2.3. MAG/C–ZnO/APT Nanocomposite Preparation
2.4. Characterization
2.5. Determination of the Minimum Inhibitory Concentration (MIC)
2.6. Cytotoxicity Assay
2.7. Statistical Analysis
3. Results and Discussion
3.1. Formation and Characterization of MAG/C–ZnO/APT Nanocomposites
3.2. Antibacterial Activities of MAG/C–ZnO/APT Nanocomposites
3.3. Cytotoxicity Test
4. Conclusions
Supplementary Materials
Author Contributions
Funding
Data Availability Statement
Conflicts of Interest
References
- Allcock, S.; Young, E.H.; Holmes, M.; Gurdasani, D.; Dougan, G.; Sandhu, M.S.; Solomon, L.; Torok, M.E. Antimicrobial resistance in human populations: Challenges and opportunities. Glob. Health Epidemiol. Genom. 2017, 2, e4. [Google Scholar] [CrossRef] [PubMed] [Green Version]
- Rawson, T.M.; Ming, D.; Ahmad, R.; Moore, L.S.P.; Holmes, A.H. Antimicrobial use, drug-resistant infections and COVID-19. Nat. Rev. Microbiol. 2020, 18, 409–410. [Google Scholar] [CrossRef] [PubMed]
- Carlet, J. The world alliance against antibiotic resistance: Consensus for a declaration. Clin. Infect. Dis. 2015, 60, 1837–1841. [Google Scholar] [CrossRef] [PubMed]
- Busch, G.; Kassas, B.; Palma, M.A.; Risius, A. Perceptions of antibiotic use in livestock farming in Germany, Italy and the United States. Livest. Sci. 2020, 241, 104251. [Google Scholar] [CrossRef]
- Jiang, S.; Lin, K.; Cai, M. ZnO nanomaterials: Current advancements in antibacterial mechanisms and applications. Front. Chem. 2020, 8, 580. [Google Scholar] [CrossRef]
- Mukhopadhya, A.; O’Doherty, J.V.; Sweeney, T. A combination of yeast beta-glucan and milk hydrolysate is a suitable alternative to zinc oxide in the race to alleviate post-weaning diarrhoea in piglets. Sci. Rep. 2019, 9, 616. [Google Scholar] [CrossRef] [PubMed]
- Huo, C.; Yang, H. Synthesis and characterization of ZnO/palygorskite. Appl. Clay Sci. 2010, 50, 362–366. [Google Scholar] [CrossRef]
- Wang, W.; Wang, A. Nanoscale clay minerals for functional ecomaterials: Fabrication, applications, and future trends. In Handbook of Ecomaterials; Martínez, L.M.T., Kharissova, O.V., Kharisov, B.I., Eds.; Springer: Cham, Switzerland, 2018; pp. 1–82. [Google Scholar]
- Aranda, P.; Ruiz-Hitzky, E. Immobilization of nanoparticles on fibrous clay surfaces: Towards promising nanoplatforms for advanced functional applications. Chem. Rec. 2018, 18, 1125–1137. [Google Scholar] [CrossRef] [PubMed]
- Cai, X.; Zhang, J.; Ouyang, Y.; Ma, D.; Tan, S.; Peng, Y. Bacteria-adsorbed palygorskite stabilizes the quaternary phosphonium salt with specific-targeting capability, long-term antibacterial activity, and lower cytotoxicity. Langmuir 2013, 29, 5279–5285. [Google Scholar] [CrossRef]
- Xu, N.; Zhou, R.; Jiang, Q.; Kong, L.; Lei, H. GEO-PGS composite shows synergistic and complementary effect on Escherichia coli and improvement of intestinal dysfunction. Food Chem. Toxicol. 2020, 135, 110936. [Google Scholar] [CrossRef]
- Hui, A.; Yan, R.; Mu, B.; Kang, Y.; Zhou, Y.; Wang, A. Preparation and antibacterial activity of ZnO/palygorskite nanocomposites using different types of surfactants. J. Inorg. Organomet. Polym. Mater. 2020, 30, 3808–3817. [Google Scholar] [CrossRef]
- Hui, A.; Yan, R.; Wang, W.; Wang, Q.; Zhou, Y.; Wang, A. Incorporation of quaternary ammonium chitooligosaccharides on ZnO/palygorskite nanocomposites for enhancing antibacterial activities. Carbohydr. Polym. 2020, 247, 116685. [Google Scholar] [CrossRef] [PubMed]
- Khan, H.; Khan, Z.; Amin, S.; Mabkhot, Y.N.; Mubarak, M.S.; Hadda, T.B.; Maione, F. Plant bioactive molecules bearing glycosides as lead compounds for the treatment of fungal infection: A review. Biomed. Pharmacother. 2017, 93, 498–509. [Google Scholar] [CrossRef] [PubMed] [Green Version]
- Jiangkun Dai, R.H.; Xu, Y.; Li, N.; Wang, J.; Dan, W. Recent progress of antibacterial natural products: Future antibiotics candidates. Bioorg. Chem. 2020, 101, 103922. [Google Scholar] [CrossRef]
- Chassagne, F.; Samarakoon, T.; Porras, G.; Lyles, J.T.; Dettweiler, M.; Marquez, L.; Salam, A.M.; Shabih, S.; Farrokhi, D.R.; Quave, C.L. A systematic review of plants with antibacterial activities: A taxonomic and phylogenetic perspective. Front. Pharmacol. 2020, 11, 586548. [Google Scholar] [CrossRef] [PubMed]
- Wang, M.; Huang, S.; Zhang, C.; Gong, H.; Cuan, S.; Wang, S.; Shao, Q.; Xu, W.; Meng, S.; Li, P.; et al. Ameliorative effects of monoammonium-glycyrrhizinate on liver lipid metabolism and antioxidant capacity in laying hens. Pak. J. Zool. 2021, 53, 1–8. [Google Scholar] [CrossRef]
- Marianecci, C.; Rinaldi, F.; Di Marzio, L.; Mastriota, M.; Pieretti, S.; Celia, C.; Paolino, D.; Iannone, M.; Fresta, M.; Carafa, M. Ammonium glycyrrhizinate-loaded niosomes as a potential nanotherapeutic system for anti-inflammatory activity in murine models. Int. J. Nanomed. 2014, 9, 635–651. [Google Scholar] [CrossRef] [Green Version]
- Asl, M.N.; Hosseinzadeh, H. Review of pharmacological effects of Glycyrrhiza sp. and its bioactive compounds. Phytother. Res. 2008, 22, 709–724. [Google Scholar] [CrossRef]
- Baltina, L.A. Chemical modification of glycyrrhizic acid as a route to new bioactive compounds for medicine. Curr. Med. Chem. 2003, 10, 155–171. [Google Scholar] [CrossRef]
- Elkhateeb, H.; AbdEl-Mongy, M.; Othman, A. In vitro detection of antibacterial activity of glycyrrhizic acid nanoparticle against ESBL producing Klebsiella pneumoniae strains. Egypt. J. Microbiol. 2018, 53, 193–205. [Google Scholar] [CrossRef]
- Chung, J.G. Inhibitory actions of glycyrrhizic acid on arylamine nacetyltransferase activity in atrains of helicobacter pylori from peptic ulcer patients. Drug Chem. Toxicol. 1998, 21, 355–370. [Google Scholar] [CrossRef]
- Zhao, X.; Zhang, H.; Gao, Y.; Lin, Y.; Hu, J. A simple injectable moldable hydrogel assembled from natural glycyrrhizic acid with inherent antibacterial activity. ACS Appl. Bio Mater. 2019, 3, 648–653. [Google Scholar] [CrossRef] [PubMed] [Green Version]
- Hedley, C.; Yuan, G.; Theng, B. Thermal analysis of montmorillonites modified with quaternary phosphonium and ammonium surfactants. Appl. Clay Sci. 2007, 35, 180–188. [Google Scholar] [CrossRef]
- Dalimov, D.N.; Isaev, Y.T.; Saiitkulov, A.M. Molecular complexes of ammonium glycyrrhizate with certain medicinal agents and their interferon-inducing activity. Chem. Nat. Compd. 2001, 37, 151–153. [Google Scholar] [CrossRef]
- Xue, Y.; Xiao, H.; Zhang, Y. Antimicrobial polymeric materials with quaternary ammonium and phosphonium salts. Int. J. Mol. Sci. 2015, 16, 3626–3655. [Google Scholar] [CrossRef] [PubMed] [Green Version]
- Wang, W.; Wang, F.; Kang, Y.; Wang, A. Nanoscale dispersion crystal bundles of palygorskite by associated modification with phytic acid and high-pressure homogenization for enhanced colloidal properties. Powder Technol. 2015, 269, 85–92. [Google Scholar] [CrossRef]
- Wahid, F.; Yin, J.J.; Xue, D.D.; Xue, H.; Lu, Y.S.; Zhong, C.; Chu, L.Q. Synthesis and characterization of antibacterial carboxymethyl Chitosan/ZnO nanocomposite hydrogels. Int. J. Biol. Macromol. 2016, 88, 273–279. [Google Scholar] [CrossRef] [PubMed]
- Maršálek, R.; Navrátilová, Z. Comparative study of CTAB adsorption on bituminous coal and clay mineral. Chem. Pap. 2011, 65, 77–84. [Google Scholar] [CrossRef]
- Fitaroni, L.B.; Venâncio, T.; Tanaka, F.H.; Gimenez, J.C.F.; Costa, J.A.S.; Cruz, S.A. Organically modified sepiolite: Thermal treatment and chemical and morphological properties. Appl. Clay Sci. 2019, 179, 105149. [Google Scholar] [CrossRef]
- Bhatt, A.S.; Sakaria, P.L.; Vasudevan, M.; Pawar, R.R.; Sudheesh, N.; Bajaj, H.C.; Mody, H.M. Adsorption of an anionic dye from aqueous medium by organoclays: Equilibrium modeling, kinetic and thermodynamic exploration. RSC Adv. 2012, 2, 8663–8671. [Google Scholar] [CrossRef]
- Jin, H.-R.; Zhou, X.-Y.; Zhu, Y.; Sun, G.-F.; Ding, S.-J.; Chen, J. Liquid-crystal behavior in Fe(OH)3/palygorskite non-aqueous dispersion. Appl. Clay Sci. 2019, 181, 105239. [Google Scholar] [CrossRef]
- Dong, W.; Lu, Y.; Wang, W.; Zong, L.; Zhu, Y.; Kang, Y.; Wang, A. A new route to fabricate high-efficient porous silicate adsorbents by simultaneous inorganic-organic functionalization of low-grade palygorskite clay for removal of Congo red. Microporous Mesoporous Mater. 2019, 277, 267–276. [Google Scholar] [CrossRef]
- Li, J.; Zheng, Y.; Feng, X.; Lv, C.; Liu, X.; Zhao, Y.; Chen, L. Adsorption removal of Ni(II) and phenol from aqueous solution by modified attapulgite and its composite hydrogel. Environ. Technol. 2021, 42, 2413–2427. [Google Scholar] [CrossRef] [PubMed]
- Middea, A.; Spinelli, L.S.; Souza, F.G., Jr.; Neumann, R.; Fernandes, T.L.A.P.; Gomes, O.d.F.M. Preparation and characterization of an organo-palygorskite-Fe3O4 nanomaterial for removal of anionic dyes from wastewater. Appl. Clay Sci. 2017, 139, 45–53. [Google Scholar] [CrossRef]
- Dahl, T.; Midden, W.R.; Neckers, D.C. Comparison of photodynamic action by Rose Bengal in gram-positive and gram-negative bacteria. Photochem. Photobiol. 1988, 48, 607–612. [Google Scholar] [CrossRef]
- Wang, L.; Yang, R.; Yuan, B.; Liu, Y.; Liu, C. The antiviral and antimicrobial activities of licorice, a widely-used Chinese herb. Acta Pharm. Sin. B 2015, 5, 310–315. [Google Scholar] [CrossRef] [PubMed] [Green Version]
- Long, D.R.; Mead, J.; Hendricks, J.M.; Hardy, M.E.; Voyich, J.M. 18beta-Glycyrrhetinic acid inhibits methicillin-resistant Staphylococcus aureus survival and attenuates virulence gene expression. Antimicrob. Agents Chemother. 2013, 57, 241–247. [Google Scholar] [CrossRef] [Green Version]
- Chakotiya, A.S.; Tanwar, A.; Narula, A.; Sharma, R.K. Alternative to antibiotics against Pseudomonas aeruginosa: Effects of Glycyrrhiza glabra on membrane permeability and inhibition of efflux activity and biofilm formation in Pseudomonas aeruginosa and its in vitro time-kill activity. Microb. Pathog. 2016, 98, 98–105. [Google Scholar] [CrossRef]
- Wahid, F.; Zhao, X.-J.; Jia, S.-R.; Bai, H.; Zhong, C. Nanocomposite hydrogels as multifunctional systems for biomedical applications: Current state and perspectives. Compos. Part B Eng. 2020, 200, 108208. [Google Scholar] [CrossRef]
- Ishikawa, S.; Matsumura, Y.; Katoh-Kubo, K.; Tsuchido, T. Antibacterial activity of surfactants against Escherichia coli cells is influenced by carbon source and anaerobiosis. J. Appl. Microbiol. 2002, 93, 302–309. [Google Scholar] [CrossRef]
- Bai, Y.; Park, I.S.; Lee, S.J.; Bae, T.S.; Watari, F.; Uo, M.; Lee, M.H. Aqueous dispersion of surfactant-modified multiwalled carbon nanotubes and their application as an antibacterial agent. Carbon 2011, 49, 3663–3671. [Google Scholar] [CrossRef]
- Oyama, K.; Kawada-Matsuo, M.; Oogai, Y.; Hayashi, T.; Nakamura, N.; Komatsuzawa, H. Antibacterial effects ofglycyrrhetinic acid and its derivatives on Staphylococcus aureus. PLoS ONE 2016, 11, e0165831. [Google Scholar] [CrossRef] [PubMed] [Green Version]
- Guan, R.; Kang, T.; Lu, F.; Zhang, Z.; Shen, H.; Liu, M. Cytotoxicity, oxidative stress, and genotoxicity in human hepatocyte and embryonic kidney cells exposed to ZnO nanoparticles. Nanoscale Res. Lett. 2012, 7, 602. [Google Scholar] [CrossRef] [Green Version]
- Han, H.-W.; Joe, A.; Jang, E.-S. Reduced cytotoxicity of CTAB-templated silica layer on gold nanorod using fluorescence dyes and its application in cancer theranostics. J. Ind. Eng. Chem. 2021, 96, 202–212. [Google Scholar] [CrossRef]
- Zhang, Y.; Xu, D.; Li, W.; Yu, J.; Chen, Y. Effect of size, shape, and surface modification on cytotoxicity of gold nanoparticles to human HEp-2 and canine MDCK cells. J. Nanomater. 2012, 2012, 375496. [Google Scholar] [CrossRef] [Green Version]
- Wahid, F.; Wang, F.-P.; Xie, Y.-Y.; Chu, L.-Q.; Jia, S.-R.; Duan, Y.-X.; Zhang, L.; Zhong, C. Reusable ternary PVA films containing bacterial cellulose fibers and ε-polylysine with improved mechanical and antibacterial properties. Colloids Surf. B Biointerfaces 2019, 183, 110486. [Google Scholar] [CrossRef]

| Samples | SBET (m2/g) | Vtotal (cm3/g) | Pore Size (nm) |
|---|---|---|---|
| ZnO/APT | 48.29 | 0.16 | 13.38 |
| C–ZnO/APT-2.5% | 53.50 | 0.17 | 12.53 |
| MAG/C–ZnO/APT-0.1% | 76.46 | 0.23 | 12.17 |
| MAG/C–ZnO/APT-0.5% | 87.98 | 0.17 | 7.89 |
| MAG/C–ZnO/APT-1% | 83.14 | 0.17 | 8.24 |
| MAG/C–ZnO/APT-2.5% | 74.54 | 0.15 | 8.19 |
Publisher’s Note: MDPI stays neutral with regard to jurisdictional claims in published maps and institutional affiliations. |
© 2022 by the authors. Licensee MDPI, Basel, Switzerland. This article is an open access article distributed under the terms and conditions of the Creative Commons Attribution (CC BY) license (https://creativecommons.org/licenses/by/4.0/).
Share and Cite
Yang, F.; Song, Y.; Hui, A.; Kang, Y.; Zhou, Y.; Wang, A. Facile Preparation of Organo-Modified ZnO/Attapulgite Nanocomposites Loaded with Monoammonium Glycyrrhizinate via Mechanical Milling and Their Synergistic Antibacterial Effect. Minerals 2022, 12, 364. https://doi.org/10.3390/min12030364
Yang F, Song Y, Hui A, Kang Y, Zhou Y, Wang A. Facile Preparation of Organo-Modified ZnO/Attapulgite Nanocomposites Loaded with Monoammonium Glycyrrhizinate via Mechanical Milling and Their Synergistic Antibacterial Effect. Minerals. 2022; 12(3):364. https://doi.org/10.3390/min12030364
Chicago/Turabian StyleYang, Fangfang, Yameng Song, Aiping Hui, Yuru Kang, Yanmin Zhou, and Aiqin Wang. 2022. "Facile Preparation of Organo-Modified ZnO/Attapulgite Nanocomposites Loaded with Monoammonium Glycyrrhizinate via Mechanical Milling and Their Synergistic Antibacterial Effect" Minerals 12, no. 3: 364. https://doi.org/10.3390/min12030364
APA StyleYang, F., Song, Y., Hui, A., Kang, Y., Zhou, Y., & Wang, A. (2022). Facile Preparation of Organo-Modified ZnO/Attapulgite Nanocomposites Loaded with Monoammonium Glycyrrhizinate via Mechanical Milling and Their Synergistic Antibacterial Effect. Minerals, 12(3), 364. https://doi.org/10.3390/min12030364








